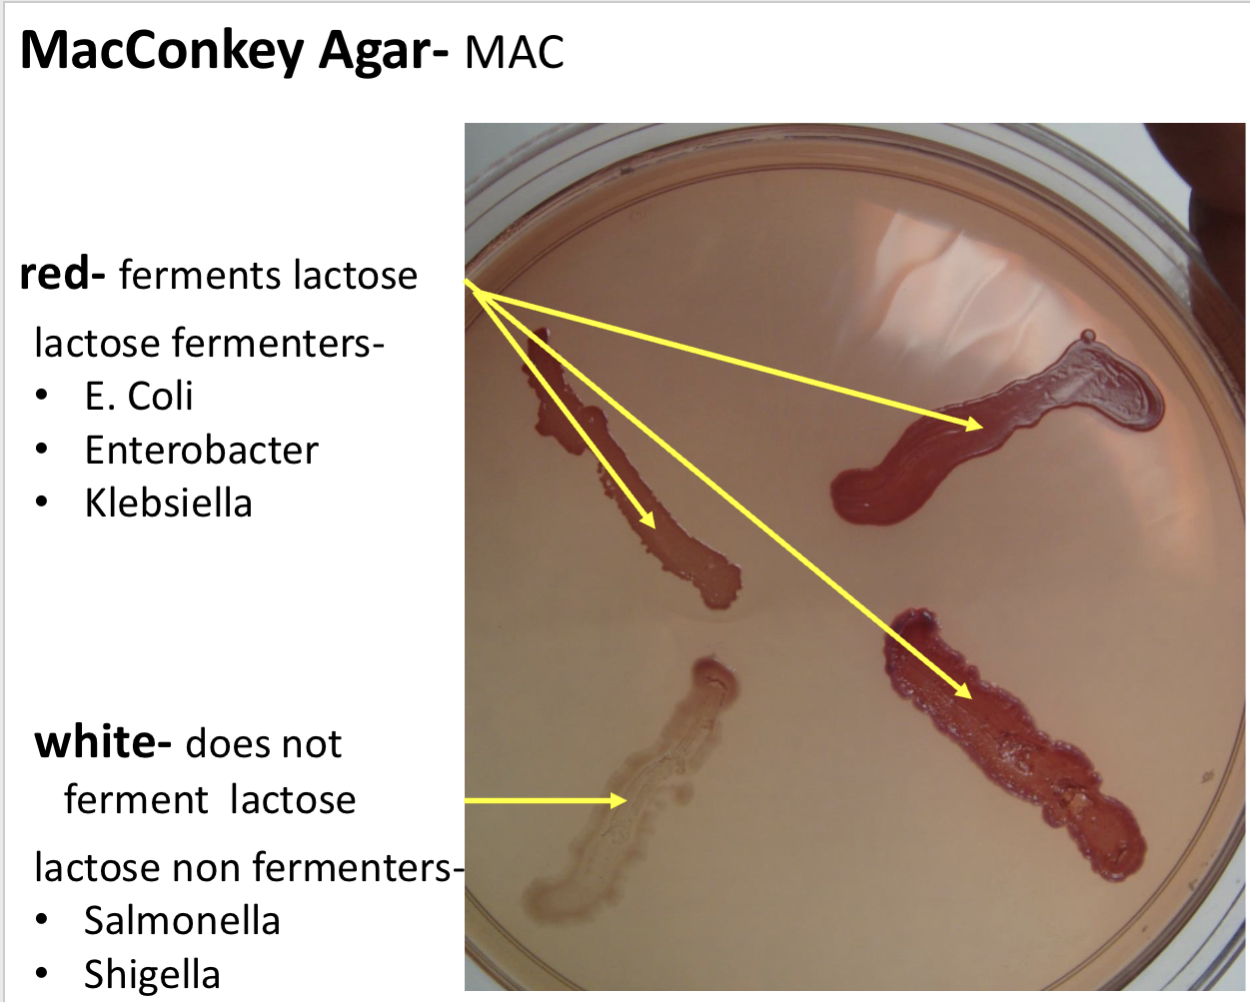
<p><span>MacConkey agar-Selective agents</span></p>
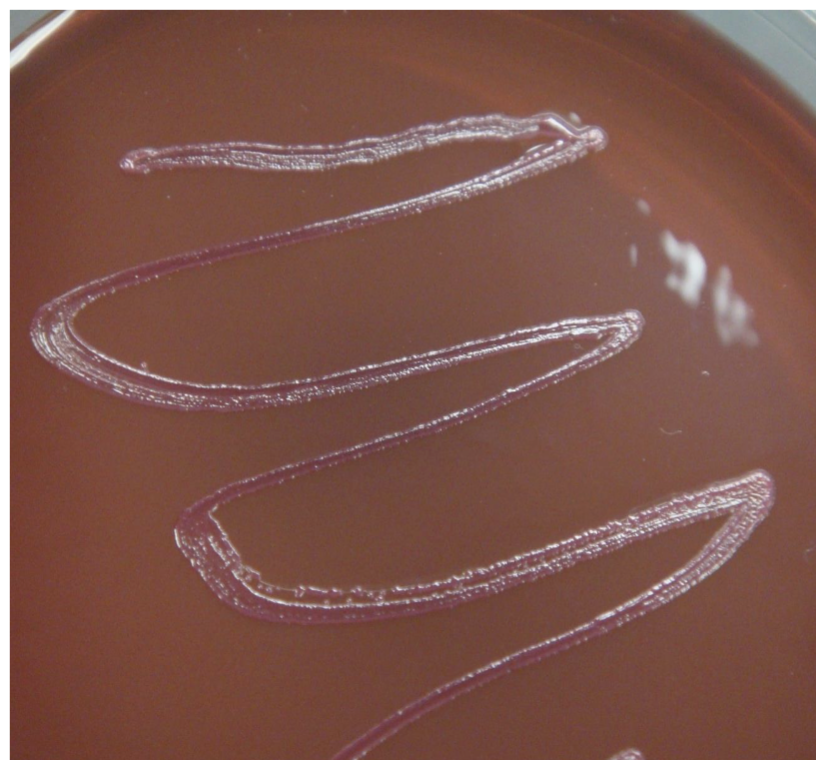
<p><span data-name="pink_heart" data-type="emoji">🩷</span> PINK / RED </p><p>EMB</p>
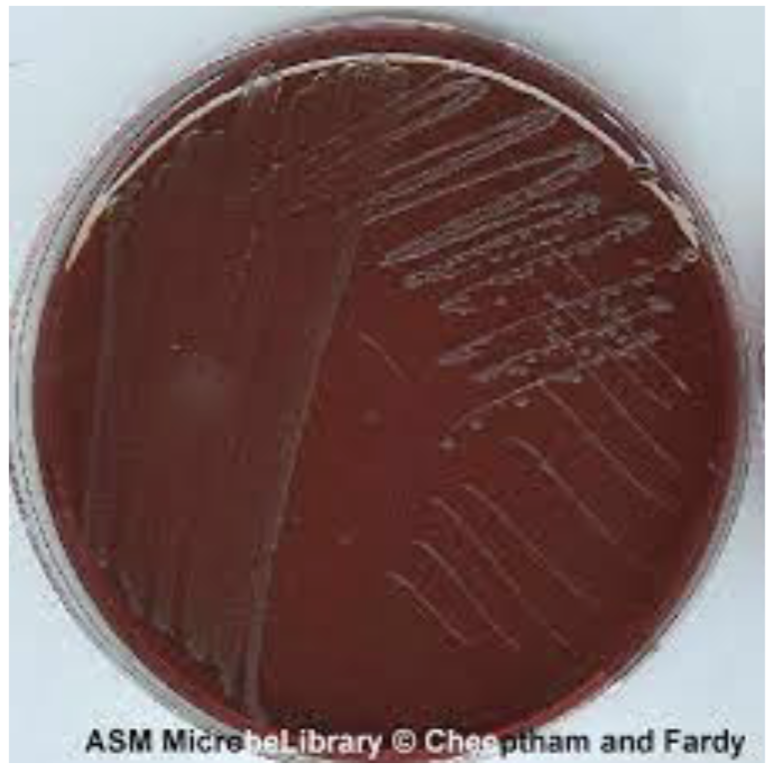
<p><span data-name="white_heart" data-type="emoji">🤍</span> COLORLESS / CLEAR </p><p>EMB</p>
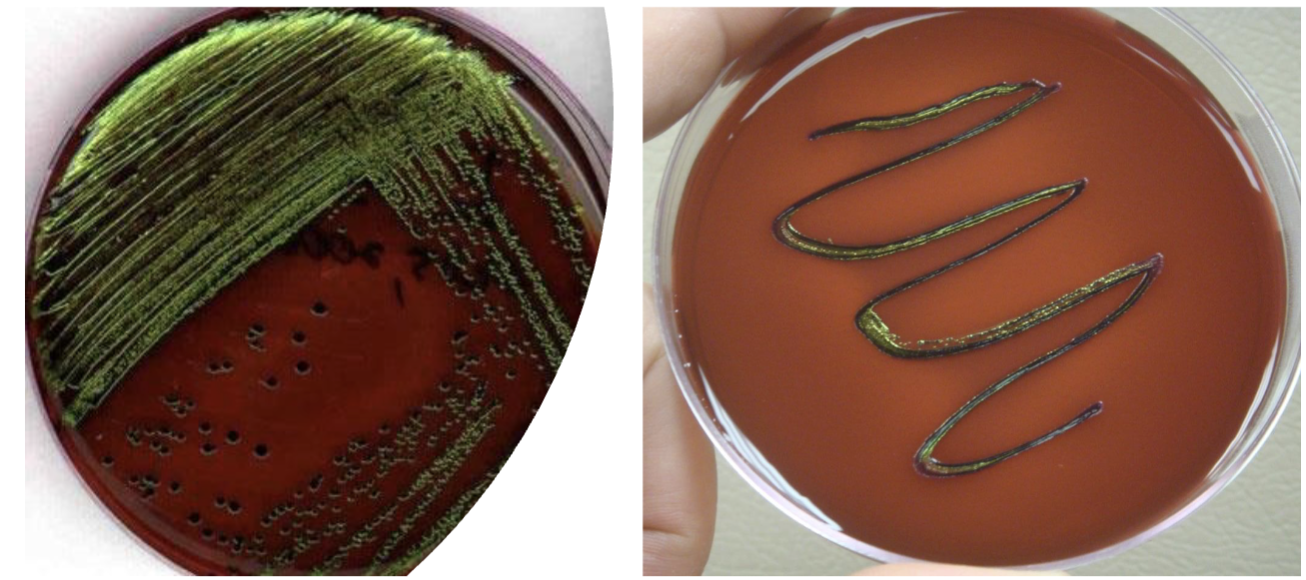
<p>Eosin Methylene Blue emb- E. coli why does it turn green?</p>
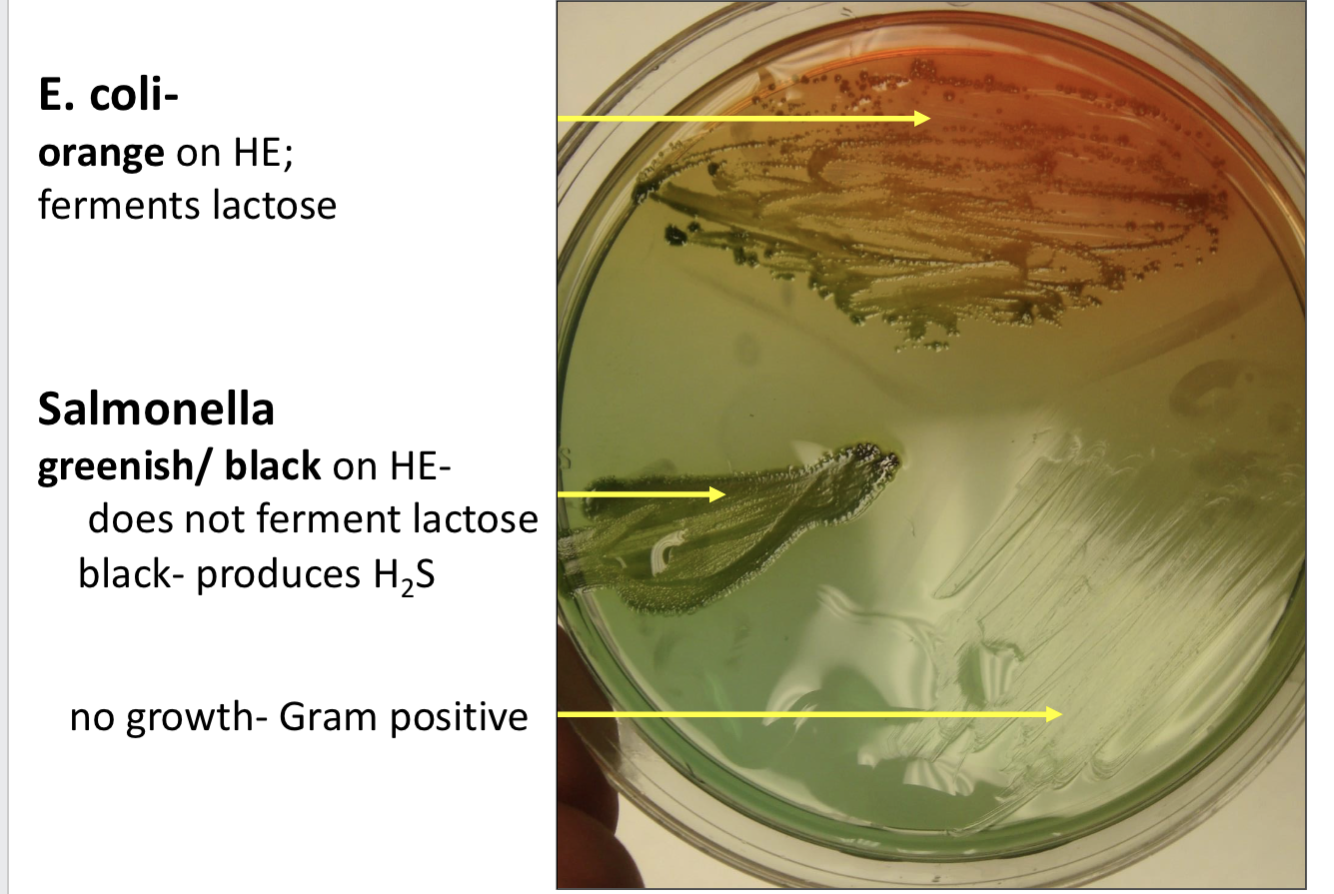
<p>HE GRAPH</p>
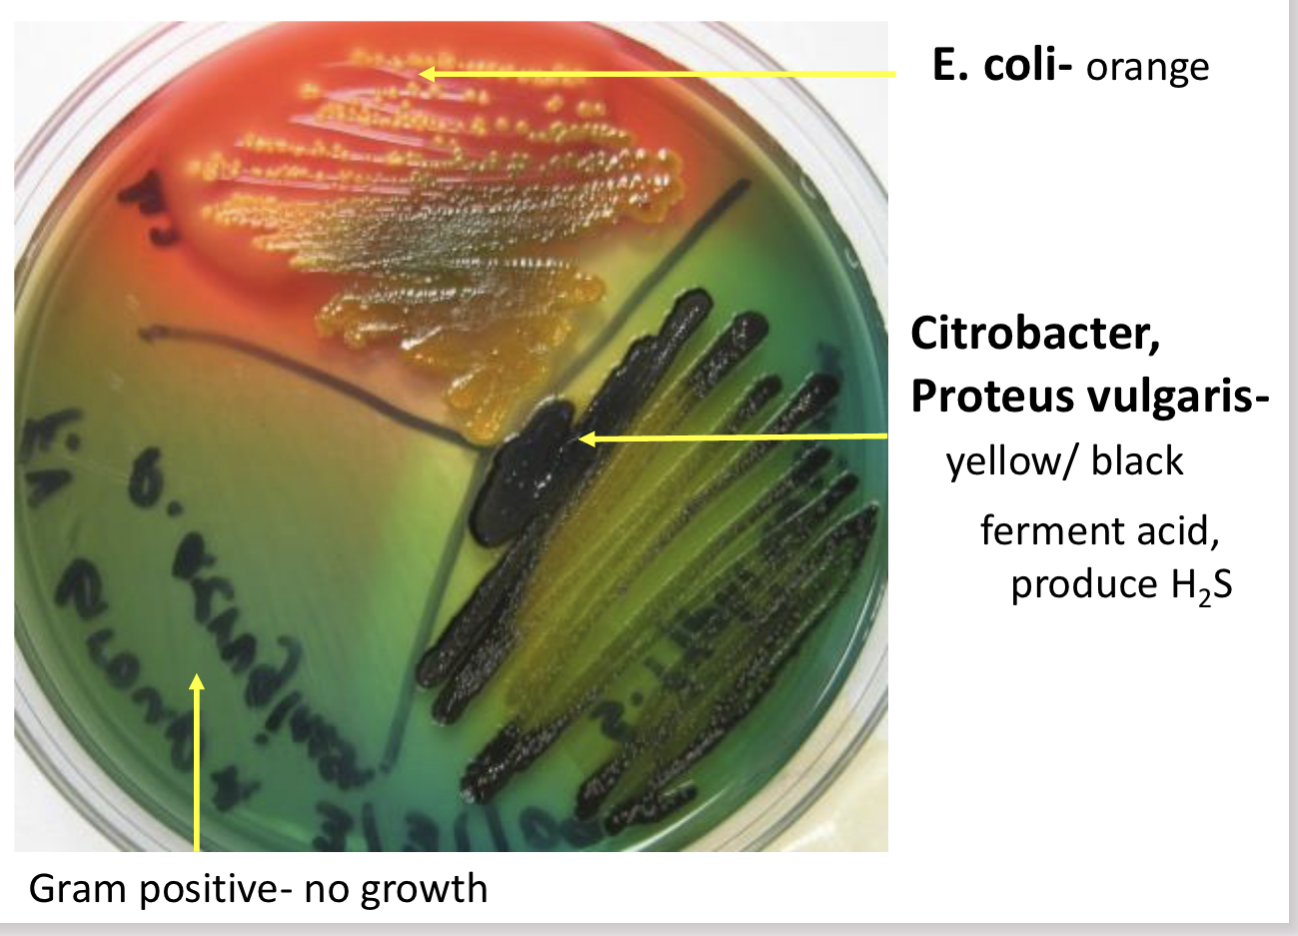
<p>Hektoen enteric agar (HE) results-<strong> Proteus vulgaris, </strong>Citrobacter</p>
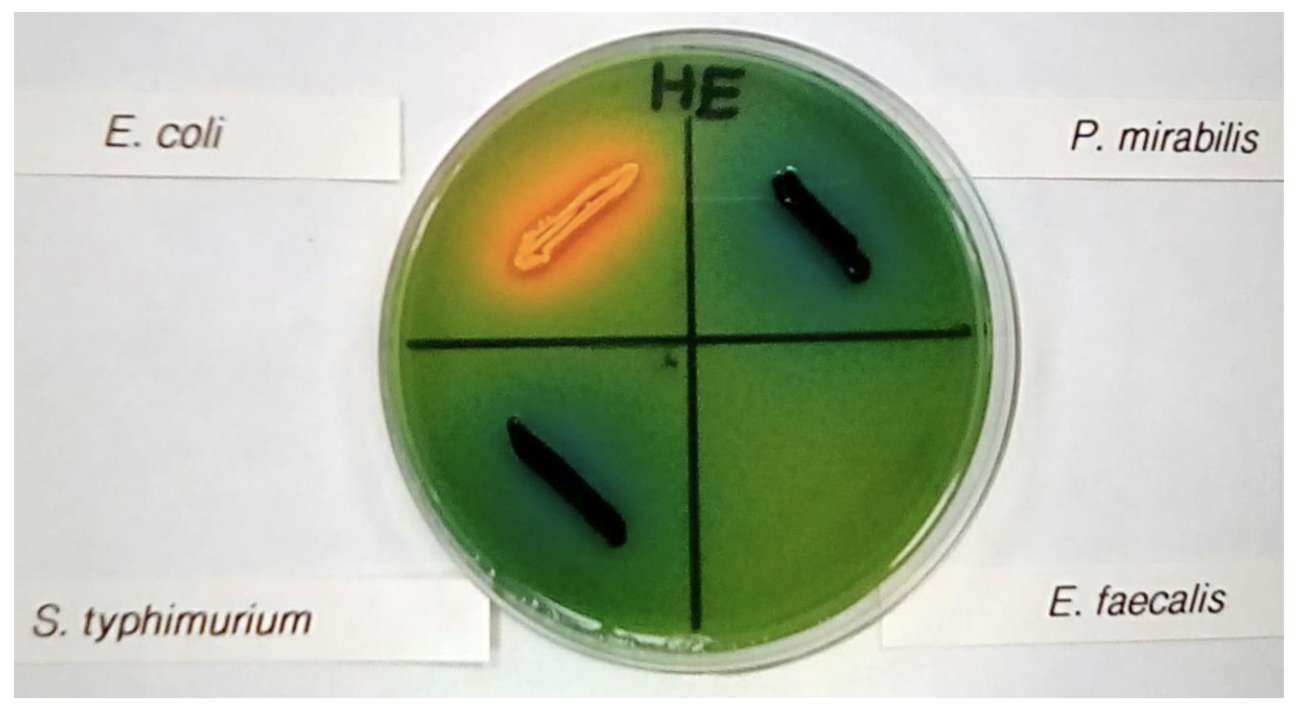
<p>what’s this?</p>
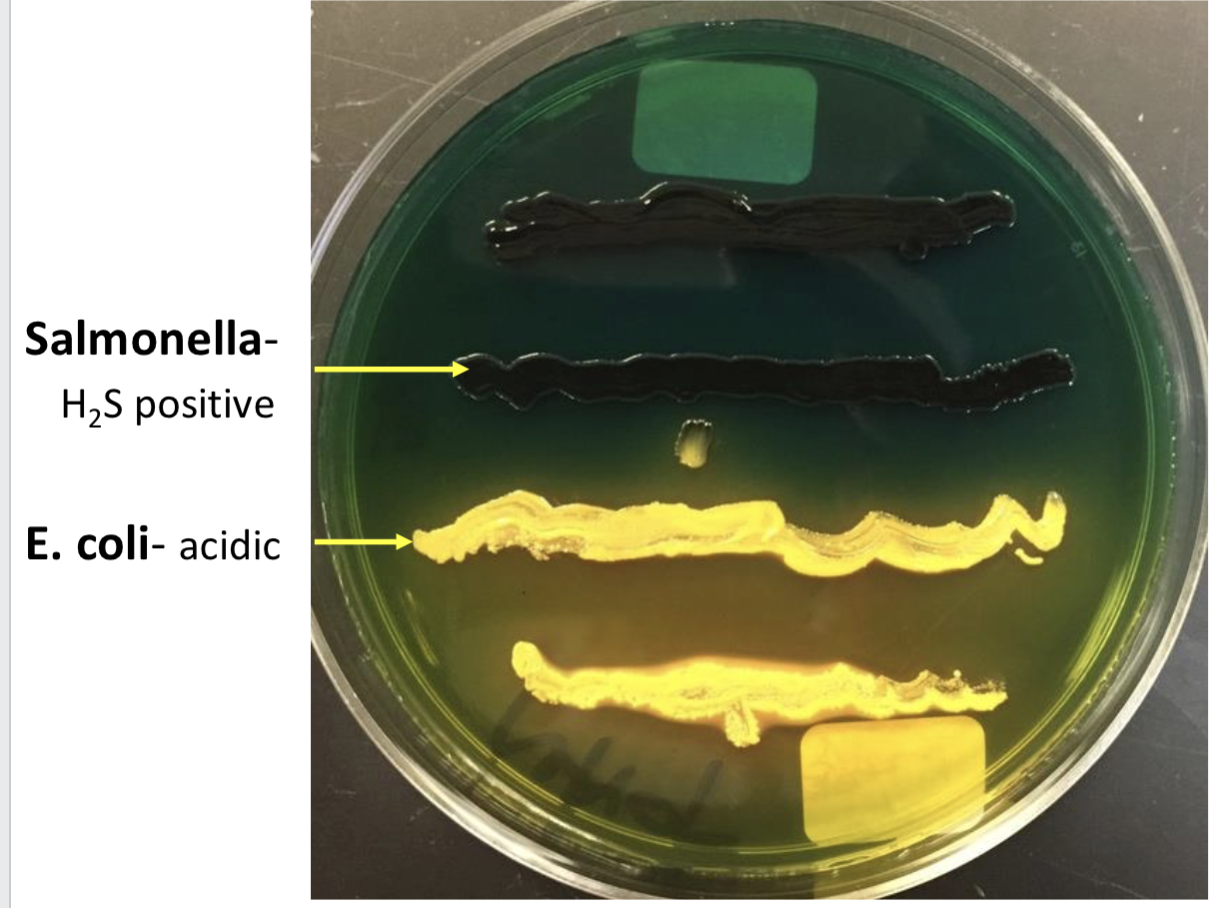
<p>what’s this?</p>

micro lab test pt.1
1/57
There's no tags or description
Looks like no tags are added yet.
Name | Mastery | Learn | Test | Matching | Spaced | Call with Kai |
|---|
No analytics yet
Send a link to your students to track their progress
58 Terms
enteric bacteria
“GUT bacteria → they EAT sugar”
E. coli, Enterobacter, Klebsiella, Salmonella
Ferment glucose ✅
Sometimes ferments lactose ✅
Oxidase negative ❌
convert nitrate to nitrite
non enteric bacteria
Alcaligenes, Pseudomonas
Do NOT ferment lactose ❌
Often don't ferment glucose (or do weird metabolism) ❌
Oxidase positive ✅
nitrate to nitrite to ammonia or gas
🧠 EASY WAY TO STUDY- ENTERIC
Enterics → oxidase NEGATIVE ❌
Enterics = gut = ferment sugar = oxidase NEGATIVE
🧠 EASY WAY TO STUDY- NON ENTERIC
Non-enterics = not gut = don't ferment lactose = oxidase POSITIVE
Non-enterics → oxidase POSITIVE ✅
✔ Convert nitrate → nitrite → ammonia or gas
MacConkey agar (MAC) is used for what?
most important media for all clinical samples except stool samples
MacConkey agar (MAC) selective for?
Gram negative bacteria
selective agents
bile salts and crystal violet
inhibit Gram positive bacteria
✅ Question 1: Who is allowed to grow? MAC
Bile salts + crystal violet = block Gram-positive bacteria ❌
So only Gram-negative bacteria grow ✅
👉 So if something grows → it's Gram-negative
🍬 Question 2: What color are the colonies? PINK
MAC
This tells you about lactose fermentation
🩷 PINK / RED colonies
Bacteria ferments lactose → makes acid
Acid turns neutral red → pink
👉 Think: “Ferments sugar = turns pink”

🍬 Question 2: What color are the colonies? 🤍 WHITE / COLORLESS colonies
MAC
Bacteria does NOT ferment lactose
No acid → stays colorless
👉 Think: “No sugar fermentation = no color”

MacConkey agar (MAC)- differential?
lactose
MAC GRAPH
Result | Meaning |
|---|---|
Growth | Gram-negative bacteria |
Pink colonies | Lactose fermenter |
White colonies | Non-lactose fermenter |

🟢 Lactose fermenters (PINK)
bacteria
E. coli
Enterobacter
Klebsiella
👉 “Gut bacteria that eat sugar → pink”

🔵 Non-lactose fermenters (WHITE)
MAC
salmonella
👉 “Don't eat lactose → stay clear”

Enterococcus- MAC does it grow?
Gram positive
does not grow on MAC
only gram negative bacteria grow
MacConkey agar-Selective agents
bile salts and crystal violet
inhibit Gram positives

Differential agent- MacConkey Agar
lactose
distinguishes Gram negatives by lactose fermentation

MAC ph indicator?
neutral red
Eosin Methylene Blue emb- used for?
water samples
Eosin Methylene Blue emb is what?
selective and differential agar
✅ Step 1: Who grows?
EMB
Eosin + methylene blue dyes + bile salts-
❌ Kill Gram-positive bacteria
✅ Allow Gram-negative bacteria
👉 If it grows → it's Gram-negative
Eosin Methylene Blue emb- selective agents?
eosin dye, methylene blue dye, bile salts
🟢 GREEN SHINY (metallic green) EMB
👉 ONLY E. coli
Strong lactose fermentation
Produces LOTS of acid
Reacts with dyes → green metallic shine
🔥Think:
“E. coli = EXTREME fermenter = GREEN shine”
🩷 PINK / RED
EMB
👉 Other lactose fermenters/ other gram negatives
EXAMPLE: ENTEROBACTER OR KLEBSIELLA
Ferment lactose
Make acid (but not as much as E. coli )
👉Think:
“Normal fermenters = pink”
🤍 COLORLESS / CLEAR
EMB
👉 Non-lactose ferments
EXAMPLE: SALMONELLA
No acid
No color change
👉 Think:
“No sugar = no color”

Eosin Methylene Blue emb- differential agent?
lactose
distinguishes Gram negatives by lactose fermentation

EMB- no growth bacteria?
gram positive
staphylococcus aureus
Eosin Methylene Blue emb- does it have a ph indicator?
NO
Eosin Methylene Blue emb- E. coli why does it turn green?
due to high acidity, motility, and metachromatic properties of dyes
too much acid

Eosin Methylene Blue emb- Salmonella
whitish
does not ferment lactose to acid
Hektoen enteric agar (HE) is used for what?
used to evaluate stool samples
Hektoen enteric agar (HE) is what type of agar?
selective and differential agar
Hektoen enteric agar (HE) selective for who?
Gram negative enterics particularly Shigella and Salmonella
👉 Mainly looking for:
Salmonella
Shigella
Hektoen enteric agar (HE) distuinguishes who?
distinguishes Shigella from Salmonella
✅ 1. Who grows?
HE
Bile salts → kill Gram-positive ❌
Only Gram-negative enterics grow ✅
Hektoen enteric agar (HE)- Selective agent
bile salts- inhibits Gram positives
Hektoen enteric agar (HE) - differential agent
lactose,
sucrose and salicin (sugar) fermentation
distinguishes Gram negatives by lactose fermentation
🍬 2. Do they ferment sugars?
HE
Sugars on HE:
lactose
sucrose
salicin
🟡 ORANGE / YELLOW
👉 Ferments sugars → makes acid
Think:
“Normal gut bacteria = eat sugar = turn yellow”
🔵 GREEN / BLUE
👉 Does NOT ferment sugars
Think:
“Pathogens (Salmonella/Shigella) = don't ferment = stay green”
Hektoen enteric agar (HE) - pH indicator
bromothymol blue
💨 3. Do they produce H₂S (hydrogen sulfide)?
HE
Peptone iron detects H₂S
H₂S + iron → BLACK color
⚫ BLACK (in colony or agar)
👉 H₂S positive
Classic for Salmonella

Hektoen enteric agar (HE) -orange/ yellow colonies and agar
ferments lactose to acid
Hektoen enteric agar (HE)-greenish/ bluish colonies and agar
color of agar
does not ferment lactose

Hektoen enteric agar (HE) results- E. coli
orange on HE
ferments lactose to acid
HE GRAPH
Color | Meaning |
|---|---|
Yellow/orange | Ferments sugars (normal bacteria) |
Green/blue | No fermentation (possible pathogen) |
Black | H₂S production (→ Salmonella) |

Hektoen enteric agar (HE) results- Salmonella
greenish blue/ black on HE
does not ferment lactose to acid
-
black- produces H2S
Hektoen enteric agar (HE) results- Proteus vulgaris, Citrobacter
yellow/ black on HE
ferments lactose to acid
black- produces H2S
what’s this?
Hektoen Enteric Agar- HE
what’s this?
Hektoen Enteric Agar- HE
oxidase test is what?
tests for cytochrome oxidase enzyme
checks if a bacterium has the enzyme “cytochrome oxidase”
👉 That enzyme is part of how some bacteria use oxygen to make energy.
oxidase test shows?
Indicates if bacterium is aerobic non enteric
cytochrome

oxidase test has what transport?
has electron transport chain similar to mitochondria ETC

oxidase reagent donates … to cytochrome oxidase
electrons

oxidase test- Enteric bacteria
cytochrome oxidase negative

oxidase test- Reagent
oxidase reagent

🔥 WHY THIS TEST MATTERS
OXIDASE test
Group | Oxidase |
|---|---|
Enterics (gut bacteria) | ❌ Negative |
Non-enterics | ✅ Positive |
Oxidase test = enzyme test
Purple = positive
No color = negative
Enterics = negative
Non-enterics = positive

oxidase test- Positive color?
blue/ black color on swab after 10 seconds
Alcaligenes - non enteric bacterium

oxidase test- Negative
not blue/ black on swab after 10 seconds
E. coli- enteric bacterium

🟣 OXIDASE POSITIVE
👉 Has cytochrome oxidase
👉 “P = Positive = Pseudomonas”
Examples:
Pseudomonas
Alcaligenes
👉 Think:
“Non-enterics = oxidase POSITIVE”

⚪ OXIDASE NEGATIVE
👉 Does NOT have cytochrome oxidase
👉 Enterics = NEGATIVE
Example:
E. coli
👉 Think:
“Enterics = oxidase NEGATIVE”